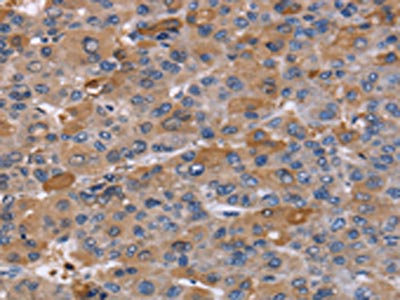

-
中文名稱:NCF2兔多克隆抗體
-
貨號:CSB-PA793109
-
規格:¥1100
-
圖片:
-
The image on the left is immunohistochemistry of paraffin-embedded Human liver cancer tissue using CSB-PA793109(NCF2 Antibody) at dilution 1/60, on the right is treated with fusion protein. (Original magnification: ×200)
-
Gel: 8%SDS-PAGE, Lysate: 40 μg, Lane: Human brain malignant glioma tissue, Primary antibody: CSB-PA793109(NCF2 Antibody) at dilution 1/200, Secondary antibody: Goat anti rabbit IgG at 1/8000 dilution, Exposure time: 5 seconds
-
-
其他:
產品詳情
-
Uniprot No.:
-
基因名:
-
別名:67 kDa neutrophil oxidase factor antibody; Chronic granulomatous disease autosomal 2 antibody; FLJ93058 antibody; NADPH oxidase activator 2 antibody; NCF-2 antibody; Ncf2 antibody; NCF2_HUMAN antibody; Neutrophil cytosol factor 2 antibody; Neutrophil cytosolic factor 2 (65kD, chronic granulomatous disease, autosomal 2) antibody; Neutrophil NADPH oxidase factor 2 antibody; NOXA2 antibody; P67 PHOX antibody; p67-phox antibody; p67phox antibody
-
宿主:Rabbit
-
反應種屬:Human,Mouse
-
免疫原:Fusion protein of Human NCF2
-
免疫原種屬:Homo sapiens (Human)
-
標記方式:Non-conjugated
-
抗體亞型:IgG
-
純化方式:Antigen affinity purification
-
濃度:It differs from different batches. Please contact us to confirm it.
-
保存緩沖液:-20°C, pH7.4 PBS, 0.05% NaN3, 40% Glycerol
-
產品提供形式:Liquid
-
應用范圍:ELISA,WB,IHC
-
推薦稀釋比:
Application Recommended Dilution ELISA 1:1000-1:2000 WB 1:200-1:1000 IHC 1:50-1:200 -
Protocols:
-
儲存條件:Upon receipt, store at -20°C or -80°C. Avoid repeated freeze.
-
貨期:Basically, we can dispatch the products out in 1-3 working days after receiving your orders. Delivery time maybe differs from different purchasing way or location, please kindly consult your local distributors for specific delivery time.
-
用途:For Research Use Only. Not for use in diagnostic or therapeutic procedures.
相關產品
靶點詳情
-
功能:NCF2, NCF1, and a membrane bound cytochrome b558 are required for activation of the latent NADPH oxidase (necessary for superoxide production).
-
基因功能參考文獻:
- We analyzed the clinical and laboratory findings of CGD with mutations in the NCF2 gene from amongst our cohort of CGD patients. A homozygous mutation (c.835_836delAC, p.T279fsX294), a deletion in NCF2 gene was found in two cases. In the third case, two heterozygous mutations were detected, IVS13-2A>T on one allele and c.1099C>T (p.) on the other allele. PMID: 28035544
- All investigated patients presented the same mutation (c.257 + 2T > C) in NCF2 gene. We show that this mutation is responsible for a drastic decrease of p67phox mRNA and leads to the skipping of exon 3 detected in the low amount of residual mRNA. PMID: 27220316
- Phosphoinositol 3-phosphate regulates reactive oxygen species production by maintaining p40phox and p67phox at the phagosomal membrane. PMID: 28096301
- TLR4- and TLR2-induced IRAK-ERK pathway cross-talks with p67phox-Nox-2 for reactive oxygen species generation, thus regulating IL-1beta transcription and processing in monocytic cells. PMID: 26320741
- Skeletal muscle protein expression of the NADPH oxidase subunits p22(phox), p47(phox), and p67(phox) was increased in obese relative to lean subjects, where p22(phox) and p67(phox) expression was attenuated by exercise training in obese subjects. PMID: 27765769
- A novel homozygous mutation in NCF2. PMID: 26272171
- results reveal an essential role for the Cys-Gly-Cys triad in Nox2 in binding p67(phox), seconded by an additional binding region, comprising residues C terminal to Cys-Gly-Cys. The 2 regions interact with distinct partner sites in p67(phox). PMID: 26160850
- This model assigns a central role to Arg-395 in the structure and stability of the quaternary NCF2/NCF4/VAV1/RAC1 NADPH oxidase complex. PMID: 25795782
- Data indicate that arachidonic acid induces the direct interaction of Rac-GTP-bound p67(phox) with the C-terminal cytosolic region of phagocyte NADPH oxidase Nox2. PMID: 25056956
- Four novel mutations in the NCF1, NCF2, and CYBB genees have been identified in chronic granulomatous disease patients in Morocco. PMID: 24596025
- Results not only establish allelic heterogeneity within NCF2 associated with SLE, but also emphasize the utility of multi-ethnic cohorts to identify predisposing variants explaining additional phenotypic variance of complex diseases like SLE. PMID: 24163247
- NCF2 in Asian populations shows a pattern of diversity characterized by a differentiated haplotype structure. PMID: 23821607
- Results provide insight into the redox-sensitive signaling mechanism that mediates cell survival involving p53 and its novel target NCF2/p67phox. PMID: 23187810
- Case Report: report defects in NCF-2, teh gene encoding p67-phox, in four cases of chronic granulomatous disease. PMID: 23264412
- Eight novel mutations in CYBB and NCF2 genes were identified in patients with chronic granulomatous disease. PMID: 22562447
- This variant reduced binding of the NCF2 gene product p67(phox) to RAC2. This study found a novel genetic association of RAC2 with Crohn's disease (CD) and replicated the previously reported association of NCF4 with ileal CD. PMID: 21900546
- NCF2 is strongly associated with increased risk of childhood- and adult-onset systemic lupus erythematosus through a single nonsynonymous coding mutation (H389Q) in exon 12. PMID: 22203994
- p67(phox) has a critical role to support for reactive oxygen species production on the level of individual phagosomes. PMID: 21954286
- Association analysis identified five SLE susceptibility genes reaching genome-wide levels of significance : NCF2 ,IKZF1 ,IRF8 ,IFIH1 , and TYK2 PMID: 22046141
- The genetic variation in the NCF2 gene was found to associate with SLE in US and European populations PMID: 20842512
- High NCF2 expression in the cytoplasm is associated with uterine cervix carcinogenesis. PMID: 21119665
- the extended activation domain of p67(phox) (amino acids 190-210) containing the D(Y/F)LGK motif plays an essential role in oxidase activation probably by interacting with gp91(phox). PMID: 20679349
- mutations in CYBB, NCF1, CYBA or NCF2 may play a role in chronic granulomatous disease PMID: 18546332
- There is an increased expression of NADPH oxidase p47(-PHOX) and p67(-PHOX) factor in idiopathic pulmonary fibrosis patients. PMID: 17651608
- All mutations and some polymorphisms identified in the NCF2 gene in the autosomal forms of chronic granulomatous disease are listed. Review. PMID: 20167518
- Here we show that p67(phox)adopts an elongated conformation when it exists not only as a monomer but also as the heterotrimer PMID: 20375610
- These findings identify the activation of PKC delta and NADPH oxidase as crucial steps in retinoic acid-induced neuroblastoma cell differentiation. PMID: 20074641
- Alu-induced deletion of the TPR4 domain of p67-phox leads to loss of function and accelerated degradation of the protein. PMID: 19953534
- In a cell-free system, covalent binding between C-terminal-truncated p67phox and rac in the correct fusion order produces a more stable complex than the individual components and significantly influences the duration of fusion-produced oxidase activation. PMID: 11705402
- detailed study of the protein-protein interactions that occur in the p40-p47-p67(phox) complex of the resting oxidase PMID: 11796733
- p22(phox), gp91(phox), p47(phox), p67(phox), and p40(phox) existed as a functional complex in the cytoskeletal fraction. PMID: 11893732
- Val204 in p67(phox), previously shown to be required for NADPH oxidase activity under cell-free conditions, was found to be essential for superoxide production by intact COS-phox cells. PMID: 11929750
- effect of cPLA2 on its translocation PMID: 12101222
- NAD(P)H oxidase subunits p47(phox) and p67(phox) are expressed in platelets; and NAD(P)H oxidase-dependent platelet superoxide anion release increases platelet recruitment. PMID: 12130503
- p67phox and p47phox have roles in regulating a change of conformation in cytochrome b558, which initiates the electron transfer in NADPH oxidase activation PMID: 12719414
- NOXO1, p47phox, and p67phox regulate Nox3 PMID: 15181005
- NAD(P)H oxidase activity is associated with increased protein levels of p22phox, p47phox, and p67phox, and increased p22phox and nox2 (gp91phox) mRNA expression. PMID: 15256399
- Increased expression and activity of NAD(P)H oxidase subunits and xanthine oxidase, in part mediated through angiotensin II and PKC-dependent pathways, are important mechanisms underlying increased oxidative stress in human coronary artery disease PMID: 16293794
- Here we show that the p47(phox)-p67(phox) interaction is disrupted not only by deletion of the PRR but also by substitution for basic residues in the extra-PRR (K383E/K385E). PMID: 16297854
- Expression of p67(phox) is regulated through mechanisms that include modulation of transcription and translation. PMID: 16310324
- These results indicate that Hcy (homocysteine)-stimulated superoxide anion production in monocytes is regulated through PKC-dependent phosphorylation of p47phox and p67phox subunits of NADPH oxidase. PMID: 16626305
- NADPH oxidase assembly from p67phox was studies at the single-cell level. PMID: 16987007
- chemoattractant-stimulated superoxide production can be amplified by a positive feedback loop in which p67(phox) targets Vav1-mediated Rac activation PMID: 17060455
- These data clearly identify PLAGL2 as a novel regulator of NCF2/p67phox gene expression as well as NADPH oxidase activity and contribute to a greater understanding of the transcriptional regulation of NCF2. PMID: 17462995
- a novel single nucleotide polymorphism in the promoter region PMID: 17712795
- Single nucleotide polymorphism leads to alternative splicing without altering gene expression or respiratory burst activity. PMID: 17910042
- p40(phox) translocates p67(phox) to the region of the cytochrome and subsequently switches the oxidase to an activated state dependent upon PtdIns(3)P and SH3 domain engagement. PMID: 18029359
- As(2)O(3) induced phosphorylation and membrane translocation of the NADPH oxidase subunit p47(phox) and it also increased translocation of Rac1 and p67(phox). PMID: 18424721
- autosomal recessive CGD due to NCF-2 gene mutations, and a novel homozygous and hypomorphic NCF-2 gene mutation was found. PMID: 18625437
- p67(phox)-SH3(N) specifically functions in gp91(phox)/Nox2 activation probably via facilitating oxidase assembly. PMID: 19116138
顯示更多
收起更多
-
相關疾病:Granulomatous disease, chronic, cytochrome-b-positive 2, autosomal recessive (CGD2)
-
亞細胞定位:Cytoplasm.
-
蛋白家族:NCF2/NOXA1 family
-
數據庫鏈接:
Most popular with customers
-
-
YWHAB Recombinant Monoclonal Antibody
Applications: ELISA, WB, IHC, IF, FC
Species Reactivity: Human, Mouse, Rat
-
Phospho-YAP1 (S127) Recombinant Monoclonal Antibody
Applications: ELISA, WB, IHC
Species Reactivity: Human
-
-
-
-
-